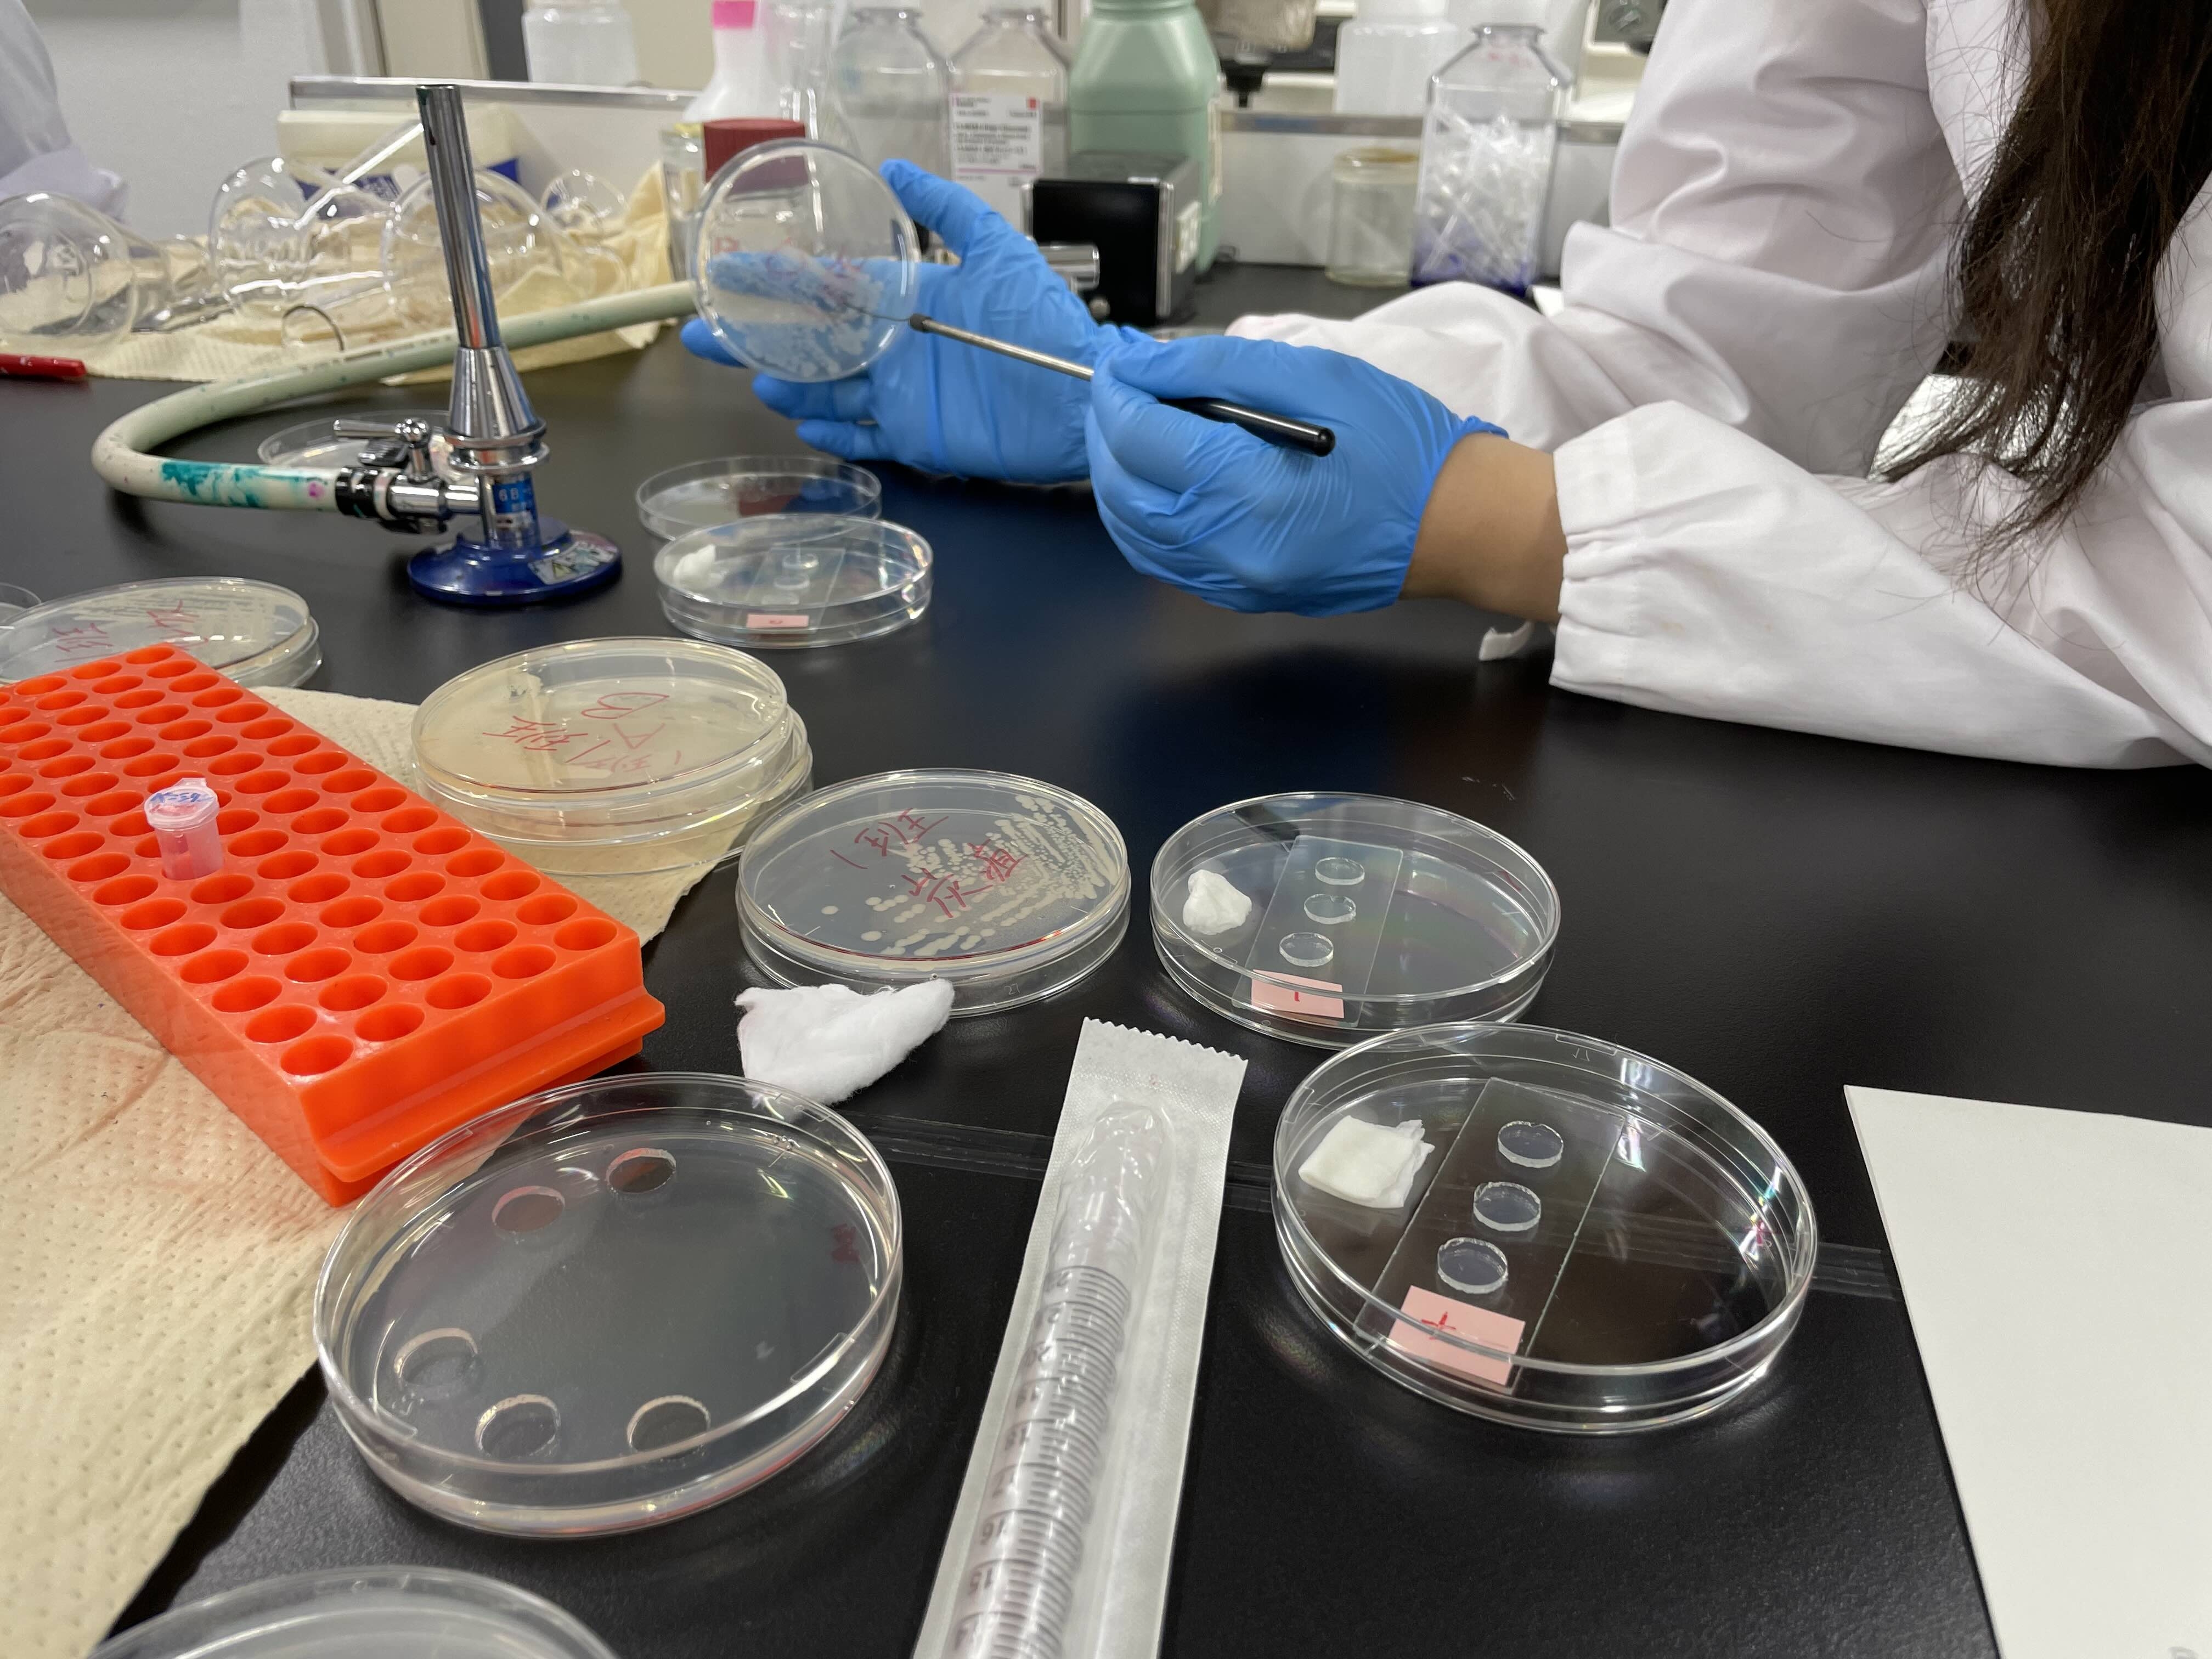

公衆衛生学実習(2025.6)
2025年10月10日
岐阜大学共同獣医学科3年生向け「公衆衛生学実習」を6月-7月の約1ヶ月間行いました。
海産魚からのアニサキス検出から狂犬病診断実習、炭疽診断実習、そして岐阜県保健環境研究所見学と
しっかり学ぶことができたと思います。
一ヶ月間、お疲れ様でした!

実習室の風景

パールテストによる炭疽菌の診断
人獣共通感染症学研究室
2025年10月10日
岐阜大学共同獣医学科3年生向け「公衆衛生学実習」を6月-7月の約1ヶ月間行いました。
海産魚からのアニサキス検出から狂犬病診断実習、炭疽診断実習、そして岐阜県保健環境研究所見学と
しっかり学ぶことができたと思います。
一ヶ月間、お疲れ様でした!

実習室の風景
パールテストによる炭疽菌の診断
All Rights Reserved, Copyright © Faculty of Applied Biological Sciences